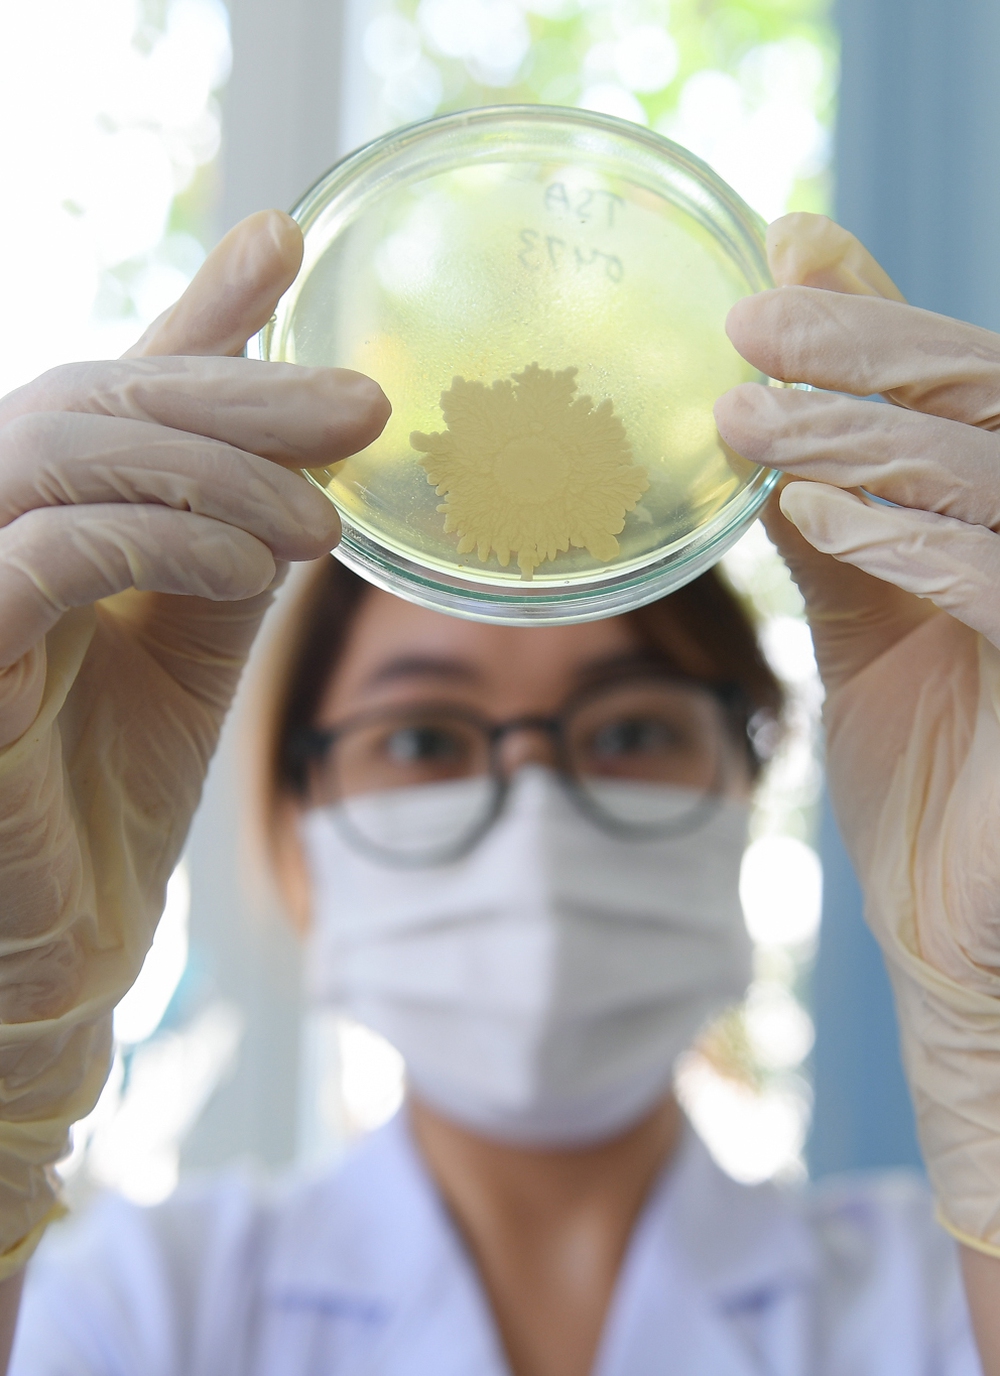

Cách đây 14 năm, ông đang ở vị trí đầy tiềm năng tại công ty mẹ Traphaco nhưng lại quyết định lên Sapa. Đó hẳn không phải là một quyết định dễ dàng?
Thời điểm năm 2010, tôi đang làm Phó Trưởng phòng nghiên cứu tại công ty mẹ (Công ty Cổ phần Traphaco – PV). Công việc thuận lợi, tôi lại có rất nhiều mối quan hệ tốt tại Hà Nội. Nên khi thấy tôi quyết định lên Sapa phát triển vùng trồng, cũng có những đồn đoán, có người còn xì xào: “Chắc ông này bị kỷ luật hay gì thì mới bị điều lên rừng thế chứ”. Tôi cũng chạnh lòng lắm vì mọi người không hiểu mình. Một người em làm cùng thì bảo: “Anh lên đó, cùng lắm 1 năm làm được mấy tấn cao actiso thì lên làm gì?”
Mọi người bên ngoài đồn như vậy, còn gia đình ông có ủng hộ không?
Tôi là người luôn chủ động với quyết định của mình nên đi hay ở phần lớn là do tôi. Rất may mắn là khi về nói chuyện với vợ, tôi đã nhận được sự đồng tình. Cũng nhờ đó, tôi phần nào yên tâm với quyết định đi phát triển vùng trồng.
Ông Đỗ Tiến Sỹ, CEO Công ty TNHH Traphaco Sapa, người đi đầu thực hiện dự án Green Plan. Ảnh: Việt Hùng
Tuy là ủng hộ, nhưng người thân cũng lo cho tôi lắm. Anh cả, khi biết tôi được điều lên Sapa còn tìm gặp lãnh đạo công ty, bảo: “Nó đi lên đấy, nếu chẳng may gặp vấn đề gì thì các anh sẽ phải chịu trách nhiệm với gia đình”.
Hồi đó, đường xá lên vùng dự án ở Sapa còn nhiều khó khăn. Đường đi như một sợi chỉ vắt từ núi này sang lưng chừng núi kia, thỉnh thoảng lại có tai nạn xảy ra nên anh trai tôi lo xa cũng là điều dễ hiểu.
Khó khăn như vậy mà ông vẫn từ bỏ nơi thuận lợi để ra đi, liệu có phải vì lãnh đạo công ty mẹ đã có hứa hẹn nào đó?
Không có bất cứ lời hứa hẹn gì của lãnh đạo, mà bản thân tôi thấy có cơ hội để phát triển bản thân. Và tôi luôn có một niềm tin dự án của mình sẽ thành công.
Cũng phải nói thêm cho bạn hiểu, là tôi nằm trong nhóm tác giả nghiên cứu Boganic, sản phẩm mà ngay lúc mới ra đời đã rất “hot” trên thị trường. Sau một năm ra mắt, doanh số Boganic đã tăng 200%.
Tôi nghĩ mình đã có thị trường tốt rồi, nếu chỉ vì không có nguyên liệu mà không thể phát triển hơn nữa thì quá phí hoài. Là một dược sĩ, tôi cũng có “máu say nghề”. Tôi không thể để “đứa con” tiềm năng này bị đối thủ lấy thị phần, nên tôi đã quyết tâm lên đường.
Nói gì thì nói, tới một nơi xa lạ, nếu không biết tiếng địa phương để hoà nhập mà chỉ có niềm tin thì cũng khó…
Đúng vậy, mọi quyết định cũng đều phải có cơ sở chứ không phải làm liều. Tôi sinh ở Ninh Bình, nhưng 13 tuổi đã theo bố mẹ lên Sơn La sinh sống. Từ lúc còn nhỏ tôi đã sống cùng với đồng bào dân tộc ít người. Nhờ đó tôi cũng được ngấm văn hoá của họ, nên tôi mới có niềm tin sẽ sớm hoà nhập được với cuộc sống ở Sapa.
Quay trở lại câu chuyện phát triển dược liệu theo hướng hiện đại hoá và làm kinh tế xanh. Đó rõ ràng là một sự lựa chọn rất khó, nhất ở thời điểm cách đây nhiều năm. Vì sao Traphaco và cá nhân ông quyết định dấn thân?
Câu chuyện này không phải là cá nhân tôi hay là Traphaco Sapa mà là hướng đi của cả công ty mẹ. Trong bối cảnh của ngành dược lúc đó (vào những năm 2000), công ty bắt buộc phải chọn hướng phát triển.
Khi đó, công ty mẹ cổ phần hoá, có nghĩa là không được bao cấp từ ngân sách của Bộ Giao thông Vận tải nữa, mà anh em phải tự nuôi sống nhau. Traphaco đứng trước sự lựa chọn quan trọng. Nếu chọn hướng đi là tân dược, chắc chắn sẽ sạt nghiệp ngay do vốn ít, không thể cạnh tranh nổi về giá, công nghệ, không chủ động được nguyên liệu…
Chúng tôi quá bé nhỏ trong ngành dược nên chọn hướng đi phát triển thuốc dược liệu từ cây cỏ sẵn có của Việt Nam. Điều này giúp chúng tôi chủ động được nguồn nhiên liệu sẵn có trong tự nhiên, tận dụng tri thức chăm sóc sức khoẻ của các dân tộc Việt Nam. Bên cạnh đó, chúng tôi sẽ không gặp phải nhiều sự cạnh tranh do các công ty dược tại Việt Nam “bỏ ngỏ” thị trường thuốc dược liệu để chạy theo tân dược.
Xác định được hướng đi chỉ có phát triển thuốc dược liệu mới có cơ hội thành công nên ngay từ rất sớm Traphaco đã lên Sapa để phát triển vùng dược liệu.
Thực tế đã chứng minh, sau nhiều giai đoạn nền kinh tế chung gặp khó khăn, thị trường chững lại thì Traphaco vẫn đang đứng vững. Và hiện nay, thuốc dược liệu đang được nhiều doanh nghiệp Việt Nam quay trở lại phát triển.
Tôi rất tò mò vì sao Traphaco lại chọn Sapa để phát triển vùng trồng?
Chúng tôi chọn Sapa phát triển vùng trồng cũng dễ hiểu thôi vì nơi đây được mệnh danh là vùng đất “Vua của cây thuốc quý”. Rất nhiều nghiên cứu chỉ ra cùng một loại cây dược liệu, ví dụ như actiso trồng tại nhiều nơi nhưng trồng ở Sapa cho hoạt chất tốt nhất.
Tại đây, bà con dân tộc ít người có những kinh nghiệm dùng thuốc dược liệu cỏ cây từ lâu đời. Đây sẽ là cơ hội để khai thác tri thức bản địa, phát triển, đưa ra giới thiệu với cộng đồng.
Năm 2010, tôi lên Sapa góp phần thực hiện dự án Green plan (phát triển vùng dược liệu bền vững cho Traphaco). Sau một năm, công ty con Traphaco Sapa ra đời, tôi làm giám đốc.
Ý tưởng dự án thì rất hay, nhưng chỉ nói chắc bà con sẽ không dễ làm theo?
Lúc đầu lên đây, tôi không biết tiếng nên gặp rào cản giao tiếp với bà con. Đi vận động bà con trồng dược liệu cho công ty phải nhờ người đi cùng phiên dịch.
Bà con cũng chẳng mặn mà gì khi nghe về dự án phát triển vùng dược liệu đâu. Vì người dân bản từ trước vốn quen với các chương trình hỗ trợ, nên vẫn nghĩ làm dự án sẽ được phát tiền ngay. Khi không thấy có tiền luôn, họ nghe mình nói mà dửng dưng như không.
Nhưng công ty xác định không cho tiền mà tạo ra mối quan hệ với người dân bản để cùng phát triển. Công ty cho người dân giống, bao tiêu sản phẩm, còn người dân có đất trồng và bỏ công chăm sóc.
Thế còn những rào cản về phong tục tập quán?
Thì chúng tôi bắt buộc phải hòa vào văn hoá của bà con dân bản thôi. Bà con vùng cao thường rất thích uống rượu nên chúng tôi muốn gần hơn với bà con thì cũng phải hòa nhập một mức nào đấy.
Mời bà con đi tập huấn sau đó sẽ là ăn nhậu, nhưng trong lúc nhậu vẫn tranh thủ “rủ rê”. Nếu như ở dưới xuôi, chúng ta uống rượu thường hô “1-2-3, dzô…”, thì khi uống với bà con trên này, chúng tôi hô “khẩu quyết”: 1-2-3 actiso… (cười).
Có một chuyện khá buồn cười, là ban đầu, khi chúng tôi mời người dân đi tập huấn thì bao giờ cũng là các ông chồng đến nghe, vì các ông thích khoản ăn nhậu. Nhưng khi về thì người làm lại toàn là các bà vợ, vì tập quán ở đây là việc nhà cửa, đồng áng do phụ nữ quán xuyến. Người làm không được nghe tập huấn thì làm sao làm đúng, nên sau đó, chúng tôi rút kinh nghiệm, đề nghị cả vợ cả chồng đi cùng. Thậm chí, hiện nay, để đảm bảo quyền lợi cho phụ nữ, chúng tôi còn yêu cầu vợ cùng tham gia ký hợp đồng với công ty.
Ngoài ra, công ty còn nhờ địa phương giúp đỡ truyền thông với bà con, công ty đang tạo kế sinh nhai xây dựng nông thôn mới, xoá đói giảm nghèo… Để làm gương, các đồng chí lãnh đạo địa phương cũng tham gia trồng atiso. Bà con thấy được sự bền bỉ của công ty, thấy cán bộ trồng thì cũng bắt đầu làm theo.
Khi bà con đã chịu trồng cây actiso thì chúng tôi đến nhà thường xuyên để hướng dẫn bằng hành động trực quan, cụ thể như cuốc đất ra sao, đặt hạt thế nào…
Nhưng thế cũng chưa phải là xong. Lúc đầu, bà con chỉ trồng cây mà không chịu chăm sóc. Tôi xuống thăm vùng trồng thấy bà con không tưới nước, mới hỏi: “Sao công ty đã thiết kế đường ống dẫn nước chỉ việc mở máy và tưới mà bà con không làm?”. Họ trả lời: “Mày chỉ nói tao trồng cây, có nói phải tưới nước đâu. Đấy cây tao trồng rồi, còn nước thì mày tự mà tưới đi”. Không còn cách nào khác, tôi lại phải tự đi cầm ống nước tưới cho cây.
Rất may là cây actiso khi trồng mỗi tháng cho thu hoạch một lần. Hàng tháng bà con đều có tiền bán actiso cho công ty nên sướng lắm. Có tiền rồi thì dễ nói hơn. Dần dần mọi người cũng hiểu cách thức làm ăn và hợp tác…
Sau này khi đã tin tưởng công ty, có hộ gia đình còn nhờ chúng tôi giữ tiền bán lá giúp tới cuối năm mới lấy. Vì cứ có tiền bán lá là người chồng đều mang đi mua rượu. Tuy nhiên, về nguyên tắc thì công ty không thể giữ tiền của dân. Tôi cũng tới gia đình nói chuyện với hai vợ chồng, chia sẻ cách quản lý tiền làm ra. Nhờ đó gia đình họ cũng hạnh phúc, no đủ.
Phát triển dược liệu phải dựa rất nhiều vào yếu tố thời tiết, địa hình, đất, nước. Trong thời gian làm dự án, ông có gặp thất bại nào không?
Tôi rất tâm đắc với câu nói của nữ thủ tướng Ấn Độ Indira Gandhi: “Tôi thích đi trên con đường gập ghềnh”. Mọi khó khăn, thất bại đối với tôi chỉ là tạm thời.
Nếu như trồng cây lương thực ông cha ta dạy nhất nước, nhì phân, tam phòng, tứ giống, thì trồng cây dược liệu sẽ khác, giống được cho là quan trọng số một. Vì giống không tốt thì trồng cây khó phát triển, năng suất thấp, ảnh hưởng trực tiếp tới thu nhập của bà con. Giống kém không đủ dược tính làm thuốc sẽ rất rủi ro cho việc chiếm lĩnh thị trường. Tại Trung Quốc, họ phát triển dược liệu chất lượng đồng đều là nhờ có kinh nghiệm chọn lọc giống cả trăm năm.
Tại Sapa, cây actiso là cây được người Pháp đưa sang Việt Nam trồng cách đây khoảng 100 năm, không tránh khỏi phân ly, thoái hoá về mặt thực vật.
Chúng tôi đã phát hiện ra chu kỳ 10 năm sẽ lặp lại vấn đề khó khăn về giống, chất lượng suy giảm, cây yếu, sản lượng thấp. Từ đó phải có biện pháp khắc phục.
Hay như cây sinh địa, công ty cũng đã đưa lên Lào Cai trồng 10 năm nay, nhưng cây không phát triển. Tới thời điểm này, chúng tôi vẫn chưa tìm ra cách phát triển cây sinh địa ở Sapa.
Xử lý sau thu hái cũng là một vấn đề. Tôi còn nhớ những chuyến xe lá actiso đầu tiên chở từ Sapa về tới Bình Lục (Hà Nam) để chế biến thì héo quắt, đen xì, dược liệu chiết xuất chẳng đáng là bao. Lần đó chúng tôi chịu lỗ hàng trăm triệu.
Do đặc tính actiso dễ bị hư hỏng nên công ty mẹ đã phải đầu tư nhà máy tại chỗ. Tôi cũng đề xuất xây dựng nhà máy GMP dù biết sẽ rất tốn kém.

Nhà máy đạt chuẩn GMP-WHO của Traphaco Sapa. Ảnh: Việt Hùng
Để xây nhà máy GMP-WHO ở một địa bàn xa như Sapa, hẳn là ông đã chịu áp lực không nhỏ?
Việc xây dựng nhà máy đạt chuẩn GMP-WHO (hướng dẫn thực hành tốt sản xuất thuốc do Tổ chức Y tế Thế giới xây dựng) ngốn rất nhiều kinh phí, nhất là ở vùng sâu vùng xa như Sapa. Thời điểm đó, có người còn bàn tán sau lưng “Ông này chắc đòi đầu tư để tư túi, xà xẻo gì đây”
Thú thật, nghe dư luận ấy, tôi buồn lắm. Nghĩ tới những đêm mưa gió, rét mướt khi mọi người chăn ấm đệm êm cùng vợ con, mình thì gần 12 giờ khuya vẫn lang thang ở sân ga chờ tàu từ Hà Nội lên Sapa mà thấy cô đơn. Lại cô đơn hơn nữa khi mình muốn làm điều tốt nhưng lại bị hiểu sai. Cảm thấy chạnh lòng, bức xúc đến nỗi muốn bỏ cuộc. Có lúc lại nghĩ như mình tự đi đày nơi gian khổ.
Nhưng cũng may, những cảm xúc cá nhân đó rồi cũng qua. Tôi nghĩ mình không thể vì một vài lời nói mà thay đổi mục tiêu. Quyết định của tôi sẽ ảnh hưởng tới lãnh đạo và anh em trong công ty, bà con dân bản, nên nếu bỏ cuộc, tôi sẽ không xứng đáng với lòng tin của mọi người. Sau này, khi mọi chuyện đã qua, tôi học được cách nghĩ thoáng hơn, giờ còn có thời gian nghiên cứu về Phật pháp nên cũng dễ buông bỏ những thứ bên ngoài hơn.
Sau khi xây dựng nhà máy vấn đề nhân sự chắc hẳn cũng không hề dễ dàng?
Tôi thu hút nhân sự bằng sự đam mê với phát triển dược liệu và đảm bảo thu nhập cho anh em ngang bằng công ty mẹ. Công ty cũng thuê nhà, tạo điều kiện để họ có thể đi lại phù hợp về thăm gia đình.
Từ chỗ chỉ có mình tôi là dược sĩ, hiện nay Traphaco Sapa đã có 8 dược sĩ, hầu hết các anh em yêu thích với công việc và muốn khẳng định mình.
Cũng có một số nhân sự trẻ khi lên Sapa có thể họ chưa đủ nhiệt đam mê với dược liệu cộng thêm đường xá xa xôi nên xin về. Điều này tôi cũng không trách được vì không thể bắt tất cả mọi người có niềm đam mê như mình được.
Thời điểm nhà máy mới đi vào vận hành, nhân sự tăng lên đột ngột cũng có sự xung đột về văn hoá giữa các nhân viên. Dần dần những vấn đề đó cũng được giải quyết, giờ anh em sống hoà thuận với nhau như một gia đình lớn.
Tới thời điểm này điều gì khiến ông tự hào nhất?
Chắc đó là công ty đã tạo được sinh kế cho đồng bào dân tộc ít người. Tôi dám khẳng định không có một công ty dược nào có cộng đồng trồng dược liệu có liên kết bền vững như Traphaco Sapa. Bà con ở đây họ quý chúng tôi. Dù họ không nói, nhưng tôi cảm nhận được tình cảm đó trong cử chỉ, hành động.
Chúng tôi đã từng bước hình thành nên mô hình phát triển dược liệu bền vững, mắt xích đầu tiên trong chuỗi giá trị xanh.
Hiện nay, Traphaco Sapa tự hào là doanh nghiệp duy nhất trong ngành dược Việt Nam là thành viên của Liên minh thương mại đa dạng sinh học đạo đức UEBT (Union for Ethical Biotrade). Chúng tôi quan tâm tới việc bảo tồn sự đa dạng sinh học, quyền lao động của phụ nữ trẻ em, bình đẳng giới.
Trong tương lai, ông và cộng sự sẽ làm gì để xây dựng các mắt xích dược liệu xanh thêm bền vững?
Chúng tôi hướng tới việc phát triển để dược liệu không chỉ làm thuốc mà sẽ gắn với mô hình du lịch trải nghiệm, chữa bệnh bằng thảo dược.
Thông qua mô hình du lịch thảo dược, chúng tôi muốn tận dụng được lợi thế của Sapa là một khu du lịch nổi tiếng. Du khách trong nước và nước ngoài có thể tới trải nghiệm các dịch vụ chăm sóc sức khoẻ, trồng, thu hái thảo dược.
Tôi kỳ vọng thông qua hình thức này, mọi người sẽ biết thêm kiến thức chăm sóc sức khoẻ bằng thảo dược. Với khách du lịch quốc tế, thông qua trải nghiệm của họ, danh tiếng về thảo dược Việt Nam có thể vượt khỏi biên giới.
Tôi cũng muốn đưa thảo dược lên bàn ăn, chế biến thành các thực phẩm bảo vệ sức khoẻ dùng hàng ngày. Hay thảo dược làm thành các mỹ phẩm làm đẹp, chăm sóc da…
Phát triển kinh tế thảo dược, cộng đồng sẽ có cơ hội chăm sóc sức khoẻ theo cách an toàn, thân thiện với thiên nhiên. Còn đồng bào miền núi sẽ được cải thiện thu nhập, phát triển tri thức là những bài thuốc truyền thống. Đặc biệt người Dao có rất nhiều loại cây dược liệu mà chỉ khi đến nhà bà con chơi, nhìn thấy trên bàn ăn mới biết.
Còn 6 năm nữa là ông sẽ nghỉ quản lý, ông có nghĩ việc đưa thảo dược lên bàn ăn sẽ thành công không?
Tôi có niềm tin là mình chắc chắn làm được.
Sapa có tiềm năng du lịch lớn, lại là nơi có nhiều thảo dược quý, điều này sẽ tạo được điểm nhấn đặc biệt với khách du lịch.
Các cụ ta vẫn thường nói: “Buôn có bạn, bán có phường”. Câu chuyện đưa bàn ăn lên bàn ăn cần có sự cộng hưởng của nhiều người cùng làm. Do vậy, chúng tôi cũng kết hợp với một số đối tác, tư vấn cho họ việc phát triển mảng ẩm thực từ thảo dược. Khách du lịch có thể được trải nghiệm đi hái dược liệu và cùng đầu bếp tại nhà hàng, khách sạn, khu nghỉ chế biến thành món ăn, nước uống tốt cho sức khoẻ.
Câu chuyện đưa thảo dược lên bàn ăn không chỉ mang lại lợi ích kinh tế. Mà giúp cho du khách hiểu hơn về cách chăm sóc sức khoẻ chủ động. Đây là hướng đi rất được kỳ vọng của công ty. Tuy nhiên còn nhiều vấn đề khách quan phải giải quyết. Ví dụ như đất ở Sapa hiện nay rất đắt đỏ. Muốn làm gì mà không có đất cũng khó khăn.
Thời gian của tôi làm giám đốc không còn nhiều nữa, vì tới tuổi tôi cũng phải nghỉ hưu. Nhưng tôi đã xây dựng được một đội ngũ nhân sự nhiệt huyết. Anh chị em sẽ làm được và làm tốt những kế hoạch tiếp theo trên con đường xanh mà chúng tôi đã lựa chọn.
Cảm ơn ông vì cuộc trò chuyện. Chúc ông sức khoẻ và thành công!
















